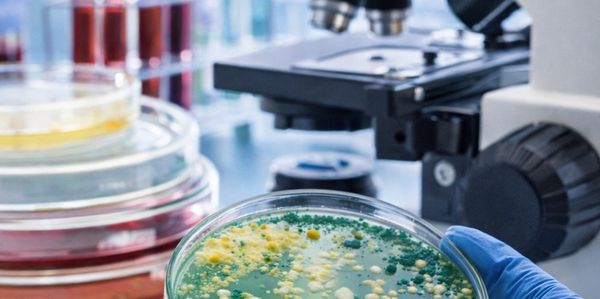

We bridge the gap between vigorous environmental stewardship and operational efficiency. By utilizing advanced in-situ bioremediation, we treat hydrocarbon and salt contamination directly at the source—without heavy machinery, soil excavation, or costly facility shutdowns associated with traditional methods. Our approach ensures your site is restored to regulatory standards while your business continues smoothly.
At PC Bioremediation, we believe that effective environmental cleanup shouldn't come at the cost of your business operations. We are an environmental services company specializing in treating hydrocarbon- and salt-contaminated soils and water.
Unlike traditional methods that require massive excavation and transport, we solve the problem at the source. Using our proprietary microbial consortia, we treat contamination in-situ (in place), restoring the land to its natural health without moving a single truckload of soil off-site.
We partner with facility managers, environmental consultants, and energy operators to turn environmental liabilities into reclaimed assets—safely, scientifically, and sustainably.

In-situ remediation treats contamination where it sits—without excavation—allowing projects to proceed faster with less disruption, reduced secondary waste, and a clearer path to closure. Ex-situ approaches (excavate, haul, and treat or dispose elsewhere) can fix the immediate problem, but they usually increase logistics, truck traffic, disposal paperwork, and ongoing handling challenges. PC Bio’s method is designed for field conditions: treat hydrocarbons and brine-related salinity on-site, preserve productive soil, and document progress with reliable sampling.

PC Bio supports asset owners and environmental teams that need fast, defensible remediation without excavation, landfill hauling, or prolonged shutdowns. We deploy in-situ biotechnology for hydrocarbon and produced-water impacts, backed by field execution and closure-focused documentation.
.png/:/cr=t:24.93%25,l:0%25,w:100%25,h:33.33%25/rs=w:600,h:300,cg:true)
Don't let contamination disrupt your business. Contact us today for a consultation and see how our in-situ solutions can save you time and money.
PC Bioremediation
Houston, TX, USA
Copyright © 2025 PC Bioremediation - All Rights Reserved.
We use cookies to analyze website traffic and optimize your website experience. By accepting our use of cookies, your data will be aggregated with all other user data.